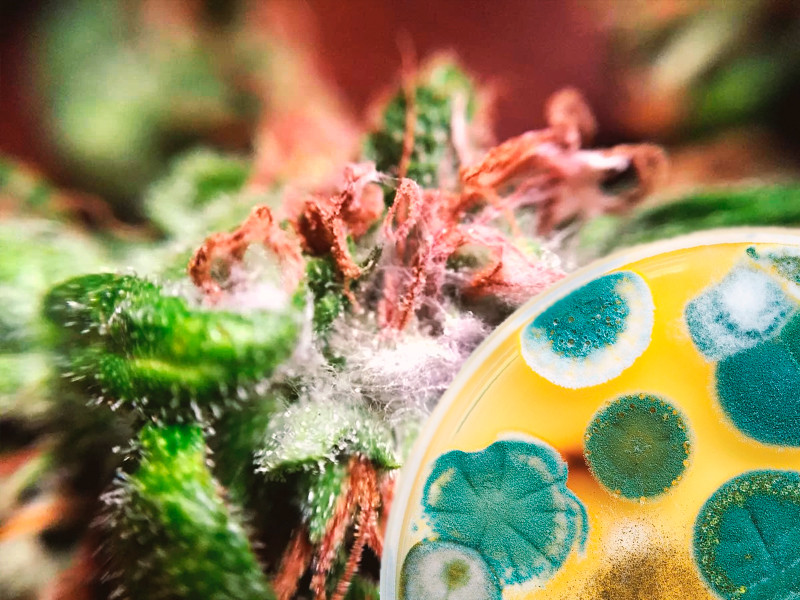
Плесень на конопле

Плесень на конопле
Плесневые грибки появились на нашей планете более 200 тыс. лет назад. Они распространены повсеместно – в воздухе, в открытом грунте, в воде. Эти грибки появляются из спор и могут поражать растения в условиях повышенной влажности. При этом плесневые грибки очень живучие, и если каннабис заразится плесенью, избавиться от нее будет не так-то просто. Плесень может покрывать поверхность грунта, поражать листья, побеги и соцветия конопли. Однажды появившись, грибок не исчезнет сам собой – нужно будет приложить усилия, чтобы вывести его.
При этом от проблемы не застрахован никто – с ней могут столкнуться не только гроверы-новички, но и продвинутые растениеводы. В данной статье мы рассмотрим причины появления плесени, ее виды, способы борьбы с заразой и меры профилактики.
Почему появляется плесень?
- Чрезмерный полив. Если поливать кусты слишком часто и давать растишкам слишком много влаги, она скапливается в их тканях, растягивая их. Из-за этого кусты теряют свой защитный барьер, у них снижается иммунитет.
- Чрезмерное питание почвы. Переизбыток удобрений ведет к тому, что растение становится вялым – пестики на соцветиях теряют свою упругость и становятся идеальным местом для размножения плесневых грибков.
- Высокая влажность воздуха и плохая вентиляция. Если во время цветения каннабиса относительная влажность превысит 55%, растение находится в зоне риска. Вероятность появления плесени значительно возрастает в гроубоксах с плохой вентиляцией, где имеет место застой воздуха.
- Скачки температуры. Понижение температуры до +16ºС – идеальная среда для размножения бактерий грибка. Ситуация усугубляется, если это сопровождается увеличением влажности, что часто бывает в осенний период.
- Высокая плотность бутонов. Такая особенность часто наблюдается у сортов с преобладанием Индики. Само по себе это неплохо, когда бутоны плотные, но здесь таится и опасность. Ближе к харвесту в таких соцветиях могут поселиться бактерии, и урожай может быть испорчен.
- Нападение насекомых-вредителей. Мотыльки, белокрылки, тля и другие насекомые-вредители сами по себе являются для растишек источником большой опасности. Они откладывают личинки на различных частях кустов. Из личинок выходят гусеницы, которые начинают активно пожирать молодую зелень. Липкие выделения, которые они оставляют на листьях и шишках, способствуют появлению еще одной проблемы в виде загнивания растения.
Разновидности плесени, поражающей коноплю

Разновидностей плесени существует великое множество, но коноплю поражает чаще всего три ее типа:
- Белая плесень. На первом этапе поражения плесень очень похожа на белую муку, рассыпанную по веерообразным листьям каннабиса. Для гровера это всегда должно быть тревожным сигналом, хотя может показаться, будто проблемы нет. Но через некоторые время пораженные «мукой» листья начинают желтеть и засыхать. Растение становится вялым и слабым, так как плесень вытягивает из него все жизненные соки.
- Красная плесень. Этот вид грибка распространяется по поверхности грунта. Сначала плесень выглядит, как белесый налет на почве, который со временем становится алым, а чуть позже – грязно-желтым.
- Серая плесень (ботритис серый). Этот вид грибка опасен своей стремительностью и внезапностью. Буквально за одну ночь он может уничтожить целый бутон! Оттенок плесени может быть разным – от бело-серого до зелено-синего.
Как бороться с плесенью?
Бороться с плесенью сложно, и часто для этого используют радикальные методы:
- Удаление пораженных листьев или всего растения. Достаточно жесткая мера, которая необходима для того, чтобы защитить соседние кусты. При удалении листьев важно соблюдать максимальную осторожность, чтобы споры плесени не попали на другие растишки.
- В случае с красной плесенью поможет удаление верхнего слоя грунта. После удаления земли нужно присыпать поверхность растолченным активированным углем, и только потом поместить новый грунт. Уголь будет выступать надежным барьером на пути распространения бактерий грибка.
- Если плесень еще сильно не разрослась, может помочь обработка почвы и растений слабым спиртосодержащим раствором.
- Обработка 0,5%-м раствором медного купороса. На 1 литр воды следует взять 5 грамм вещества.
- Использование фунгицидных препаратов.
Меры профилактики

- Тщательный контроль условий выращивания каннабиса (температуры, уровня влажности, дозировки удобрений, количества и качества воды для полива).
- Постоянный осмотр листьев и соцветий. Это поможет вовремя выявить проблему с появлением плесени – на начальной стадии бороться с заболеванием будет гораздо проще.
- Организация хорошей вентиляции, препятствующей застою воздуха в гроубоксе.
- Удаление с грунта опавшей листвы, под которой часто скапливается влага, и это стимулирует распространение грибка.
- Тщательный осмотр плотных соцветий каннабиса за 14 дней до харвеста. Особенно плотные бутоны нужно раскрыть или вовсе обрезать, чтобы избежать загнивания всего куста.
- При аутдорном гровинге желательно стряхивать с листьев утреннюю росу, чтобы свести риск заражения к минимуму.
Плесень – то заболевание, которое гораздо проще предотвратить, чем добиться полного излечения кустов. Вот почему лучше заранее принять меры и не допустить появления плесневелого грибка.
